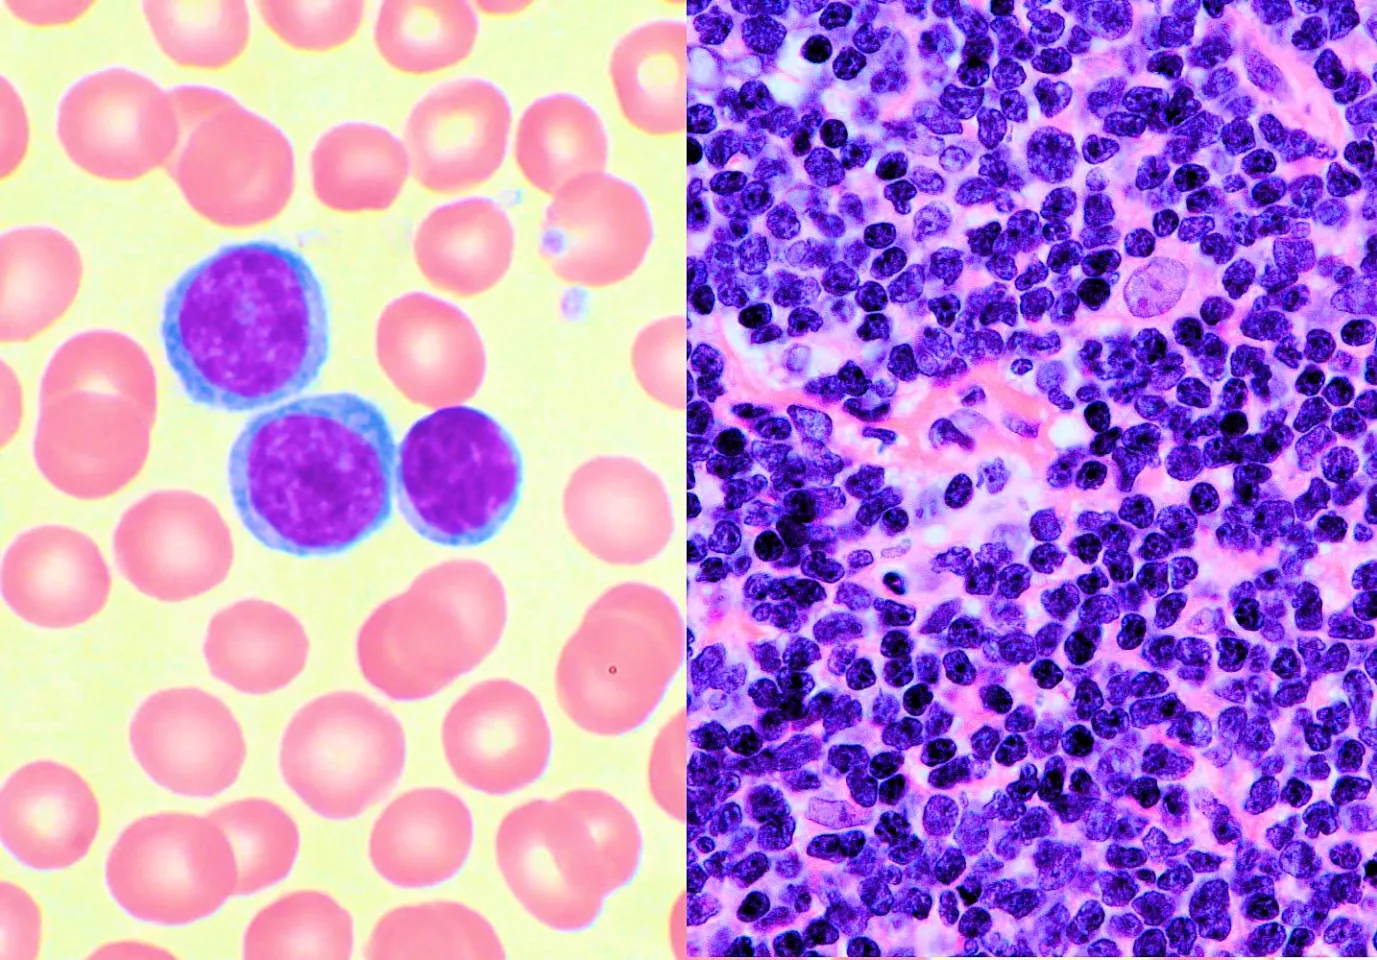

If a locked door must be opened, explosives can be used, but normally it is better to use a key. The conventional treatments for cancer, surgery, radiation, and chemotherapy, have a range of terrible side effects that resemble the use of explosives. Now a key has been found to treat various forms of leukemia and lymphoma with only very minor side effects. The drug ibrutinib has proven sufficiently safe and effective in early clinical tests by physicians at Ohio State University that it has been given breakthrough drug status by the FDA.
Both chemotherapy and radiation treatment protocols for cancer have one primary goal – design a treatment that is slightly more lethal to the cancer than to the patient. Chemotherapy began nearly 100 years ago, when mustard gas derivatives were studied following World War I. From this early start, serious research on chemotherapy agents for cancers began around 1950. While chemotherapy is still one of the key weapons to use in fighting cancer, a good deal of pharmaceutical and medical research is presently going toward more targeted agents to minimize the enormous stress of cancer therapy on the patient.
Leukemia and lymphoma are cancers of the blood. Leukemia is the proliferation of immature white cells in the blood, which leads to impairment of the immune system, blood clotting issues, and red cell anemia. Lymphoma is a similar proliferation of lymphocytes, which has similar symptoms, but can also involve solid tumors of the lymph nodes. In both cancers, complete cure is unlikely, but the disease can be managed in most cases by triggering partial or complete periods of remission through chemotherapy and/or radiation treatment. As these treatments are still painful and debilitating, and sometimes ineffective, new forms of treatment are an active area of research.
![The chemical structure of ibrutinib (1-[(3R)-3-[4-amino-3-(4-phenoxyphenyl)pyrazolo[3,4-d]pyrimidin-1-yl]piperidin-1-yl]prop-2-en-1-one) (Image: National Library of Medicine)](https://assets.newatlas.com/dims4/default/206b874/2147483647/strip/true/crop/562x473+0+0/resize/562x473!/format/webp/quality/90/?url=https%3A%2F%2Fnewatlas-brightspot.s3.amazonaws.com%2Farchive%2Fnew-lymphoma-treatment-leukemia-cancer-ibrutinib-3.jpg)
Ibrutinib is a member of a new class of drugs for use against B-cell blood cancers. B-cells are a type of white blood cell that is active in the body's immune system. They have B-cell receptor (BCR) proteins on the cell surfaces, which binds to specific bodily invaders, thereby allowing the immune system to attack the invaders. B-cells also act as part of the memory function of the immune system, keeping a chemical record of past targets of the immune reaction. Malfunctioning B-cells can cause autoimmune diseases as well as becoming cancerous themselves.
In B-cells, an enzyme called Bruton's tyrosine kinase (BTK) is an important stage in the B-cell maturation and activation of the BCR proteins. Among other functions, this BCR signaling is thought to drive the growth and well-being of many types of B-cell cancers. In short, B-cell cancers have a very difficult time surviving in the absence of BTK.
Ibrutinib is a strong covalent inhibitor of BTK, and in inhibiting BTK triggers B-cells to undergo apoptosis, or cell death, effectively blocking cancer growth and metastasis. Ibrutinib also shows activity in treatment of autoimmune disease, by throttling back the action of the immune system.
A new clinical trial carried out by medical researchers at Ohio State University Comprehensive Cancer Center in cooperation with MD Anderson Cancer Center, investigated the effect of ibrutinib in two groups of patients, one having confirmed recurring or resistant cases of chronic lymphocytic leukemia (CLL) and the other having confirmed recurring or resistant cases of mantle cell lymphoma (MCL). Neither study involved a control group or healthy patients, as the object was to determine the toxicity and efficacy of the ibrutinib treatments.
The CLL trial involved 85 ambulatory patients, 51 of whom received ibrutinib at 420 mg/day, and 34 who received 840 mg/day. Ibrutinib can be absorbed by mouth, so the doses were given orally. The lower dose group included a third group, originally excluded from the study because of high-risk genetic factors, who showed no response to chemoimmunotherapy. The early results of the clinical study proved sufficiently positive that exclusion of the third group was judged to be inappropriate.
Treatment with ibrutinib proved to be very safe, with most participants only encountering annoying side effects that did not require stopping the treatment. Only six patients were forced to halt treatment, primarily due to diarrhea and the associated dehydration, and upper respiratory tract infections.
The treatment was also very effective at stopping progression of CLL, and in most cases (71 percent) causing at least a partial remission. The results were independent of the doses used, which argues toward using smaller doses. The response was somewhat better (85 percent) in patients lacking high-risk genetic mutations. Overall, the 26-month survival rate was 83 percent, with little dependence of age or stage of the cancer at the start of participation in the study.
The MCL trial included 111 ambulatory patients, all of whom received 560 mg/day of ibrutinib. Nearly all of the patients had previously received multiple rounds of chemotherapy, and 86 percent had intermediate or high-risk lymphoma.
The ibrutinib treatment proved quite effective, with 21 percent of the patients experiencing a complete remission of MCL, and another 47 percent having a partial remission. The estimated total rate of survival at 18 months was 58 percent. Again, a remarkable feature of the trial is that ibrutinib helped nearly all patients to one extent or another.
“This is remarkable because the last agent approved by the Food and Drug Administration for MCL had a 30 percent response rate,” says senior author Kristie Blum, MD, associate professor of medicine, and head of the OSUCCC – James lymphoma program. “This trial suggests that ibrutinib could significantly improve the landscape of therapy options for MCL.”
The level of response found to ibrutinib could only be approached through conventional chemotherapy by intensive, multiagent regimes of treatment associated with very high toxicity. Ibrutinib is clearly on the fast track to approval for treating a range of B-cell cancers. Hopefully it becomes a standard therapy option before any reader needs such treatment.
Source: Ohio State University